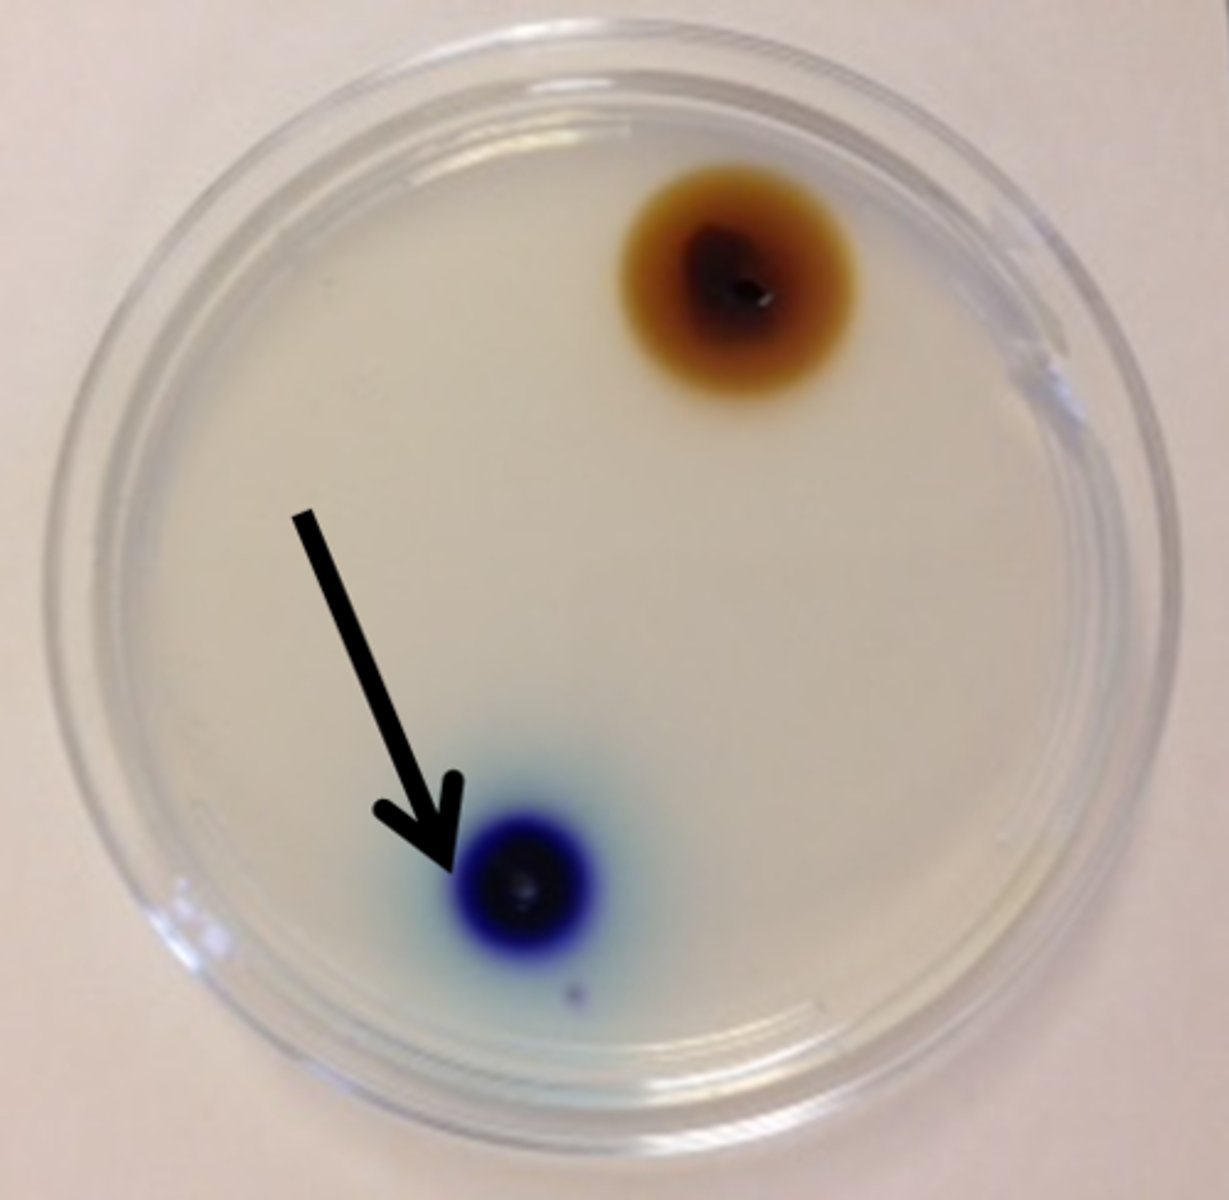

BIOL 2401 Ex 3 Set 4
0.0(0)
0.0(0)
New
Card Sorting
1/3
There's no tags or description
Looks like no tags are added yet.
Study Analytics
Name | Mastery | Learn | Test | Matching | Spaced |
|---|
No study sessions yet.
4 Terms
1
New cards
Largest molecular weight
2
New cards
hypertonic

3
New cards
hypotonic

4
New cards